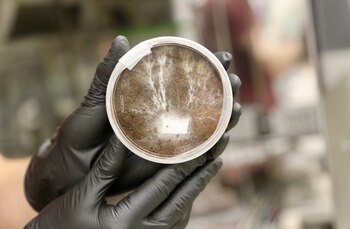
Las casas a base de

La NASA está explorando nuevas tecnologías para construir casas a base de hongos. Este tipo de estructuras podría ser una solución sustentable para generar viviendas en la Tierra así como en Marte y otros planetas. Sí, eso que suena tan futurista, como vivir en otros planetas hoy parece estar cada vez más cerca. Prueba de ello son los avances y las investigaciones que se están haciendo con este objetivo en mente.
El Centro de Investigación Ames de la NASA, ubicado en Silicon Valley, está trabajando en iniciativas para crear estructuras a partir de hongos y los hilos que constituyen esos hongos, que se conocen como micelios. Más precisamente se denomina micelio al conjunto de hifas, que son filamentos pluricelulares y que pueden crecer con mucha rapidez. Las hifas tienen varias funciones vinculadas con la nutrición, crecimiento y reproducción.
Estos pequeños hilos que constituyen los micelios se ramifican y construyen estructuras precisas y complejas. La idea detrás de esta iniciativa es programar los micelios para que conformen nuevas estructuras, generar materiales resistentes que podrían ser usados como ladrillos ecológicos.

Eventualmente este proyecto permitiría a los primeros humanos que vayan a habitar Marte, la Luna u otro planeta tener una vivienda compacta hecha a base de hongos inactivos. La idea es poder trasladar estructuras de bajo peso en un viaje tan largo como el que implica ir desde la Tierra a su satélite natural, el Planeta Rojo o eventualmente a otros lugares también. El material resultante tiene mayor curva de resistencia que el hormigón, así como mejor resistencia a la compresión que la madera, según los investigadores.
"Cuando diseñamos para el espacio, somos libres de experimentar con nuevas ideas y materiales con mucha más libertad que en la Tierra", dijo Lynn Rothschild, investigador principal del proyecto, en el comunicado publicado por la NASA. Y añadió: “después de que estos prototipos estén diseñados para otros mundos, podemos traerlos de vuelta al nuestro".
Cómo se construirán las viviendas
Una vez que se llegue a destino, a esta estructura base se le añadirá agua y los hongos crecerán hasta darle forma a un hogar sustentable, diseñado de modo tal que no genere contaminación ambiental. Esta investigación parte de un campo de estudio conocido como biología sintética, que se basa en la idea de diseñar organismos que puedan ser programados o reutilizados para cumplir nuevas funciones, como en este caso.

¿Cómo se haría esta construcción? Para que los hongos puedan vivir necesitan nutrirse, tal como cualquier otro organismo vivo. En el marco de este proyecto, el micelio se alimentará de cianobacterias, que son capaces de hacer fotosíntesis. Es decir que esta bacteria usa la energía solar para convertir el agua y el dióxido de carbono en oxígeno y alimento para los hongos.
Las casas a base de micelio estarán conformadas por tres capas: la capa más externa estará hecha de hielo, que se haría con agua extraída de la Luna o Marte. Este elemento servirá como protección contra la radiación. Luego habrá una segunda capa hecho por cianobacterias que se nutrirán del agua de la primera capa y, por medio de un proceso de fotosíntesis producirían oxígeno y nutriente para los humanos que vivan allí, así como para la tercer capa de estas viviendas que estaría conformada por micelios. Esta capa de micelios crecerá y conformará una estructura orgánica y resistente en un ambiente contenido. Una vez que se logre el desarrollo completo de la vivienda, se hornearía para matar los hongos y evitar que continúen creciendo y que dañen el medio ambiente.
Los micelios podrían usarse para otros fines también, como la biominería por ejemplo, que consiste en el empleo de bacterias para catalizar la extracción de minerales de aguas residuales. También podría ser de utilidad para desarrollar hábitats capaces de regenerarse y así reparar las zonas dañadas de forma automática; regular la humedad o para proporcionar iluminación bioluminiscente, que es el proceso mediante el cual los organismos vivos producen luz. Esto es el resultado de una reacción bioquímica en la que suele intervenir una enzima llamada luciferasa. Por otra parte, este tipo de construcción sería una alternativa sustentable en la Tierra, para reducir las emisiones de carbono que vienen de la construcción tradicional.
Cabe señalar, una vez más, que todo esto es una iniciativa. Es el inicio de un proyecto que podría avanzar hasta hacerse realidad o bien podría ser desechado para avanzar con alguna otra solución superadora. Lo que deja en claro se que observar la naturaleza y basarse en elementos presentes en nuestro hábitat podría ser la respuesta para crear soluciones sustentables.
MÁS SOBRE ESTE TEMA:
Últimas Noticias
Salir de un grupo de WhatsApp en modo incógnito es posible
La actualización está activa para iPhone y teléfonos Android

Apple Music lanza “Replay”, una lista de canciones preferidas cada semana
La recopilación de canciones favoritas será actualizada cada domingo hasta el final del año 2023

Inteligencia artificial elimina marcas de agua en fotografías
Según WatermarkRemover, estos sellos que garantizan los derechos de autor también arruinan la estética de las fotografías

Así se puede usar un iPhone como traductor de idiomas, sin internet
La aplicación de Traducción se encuentra instalada de forma predeterminada en los celulares de Apple y puede descargarse desde la App Store

Juegos de rol en TikTok: “escoge tu aventura” es el nuevo desafío
Los usuarios aprovechan las herramientas de la red social para proponer escenarios entretenidos a sus seguidores



